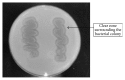

Extracellular Polyhydroxyalkanoate Depolymerase by Acidovorax sp. DP5
- PMID: 26664741
- PMCID: PMC4664802
- DOI: 10.1155/2015/212159
Extracellular Polyhydroxyalkanoate Depolymerase by Acidovorax sp. DP5
Abstract
Bacteria capable of degrading polyhydroxyalkanoates (PHA) by secreting extracellular depolymerase enzymes were isolated from water and soil samples collected from various environments in Malaysia. A total of 8 potential degraders exhibited clear zones on poly(3-hydroxybutyrate) [P(3HB)] based agar, indicating the presence of extracellular PHA depolymerase. Among the isolates, DP5 exhibited the largest clearing zone with a degradation index of 6.0. The highest degradation activity of P(3HB) was also observed with depolymerase enzyme of DP5 in mineral salt medium containing P(3HB). Based on biochemical characterization and 16S rRNA cloning and sequencing, isolate DP5 was found to belong to the genus Acidovorax and subsequently named as Acidovorax sp. DP5. The highest extracellular depolymerase enzyme activity was achieved when 0.25% (w/v) of P(3HB) and 1 g/L of urea were used as carbon and nitrogen source, respectively, in the culture media. The most suitable assay condition of the depolymerase enzyme in response to pH and temperature was tested. The depolymerase produced by strain Acidovorax sp. DP5 showed high percentage of degradation with P(3HB) films in an alkaline condition with pH 9 and at a temperature of 40°C.
Figures

References
-
- Kachrimanidou V., Kopsahelis N., Papanikolaou S., et al. Sunflower-based biorefinery: poly(3-hydroxybutyrate) and poly(3-hydroxybutyrate-co-3-hydroxyvalerate) production from crude glycerol, sunflower meal and levulinic acid. Bioresource Technology. 2014;172:121–130. doi: 10.1016/j.biortech.2014.08.044. - DOI - PubMed
-
- Brandl H., Püchner P. Biodegradation of plastic bottles made from ‘Biopol’ in an aquatic ecosystem under in situ conditions. Biodegradation. 1991;2(4):237–243. doi: 10.1007/bf00114555. - DOI
-
- Byrom D. The synthesis and biodegradation of polyhydroxyalkanoates from bacteria. International Biodeterioration and Biodegradation. 1993;31(3):199–208. doi: 10.1016/0964-8305(93)90005-m. - DOI
-
- Doi Y. Microbial Polyesters. New York, NY, USA: Wiley-VCH; 1990.
-
- Steinbüchel A., Valentin H. E. Diversity of bacterial polyhydroxyalkanoic acids. FEMS Microbiology Letters. 1995;128(3):219–228. doi: 10.1016/0378-1097(95)00125-O. - DOI
LinkOut - more resources
Full Text Sources
Other Literature Sources